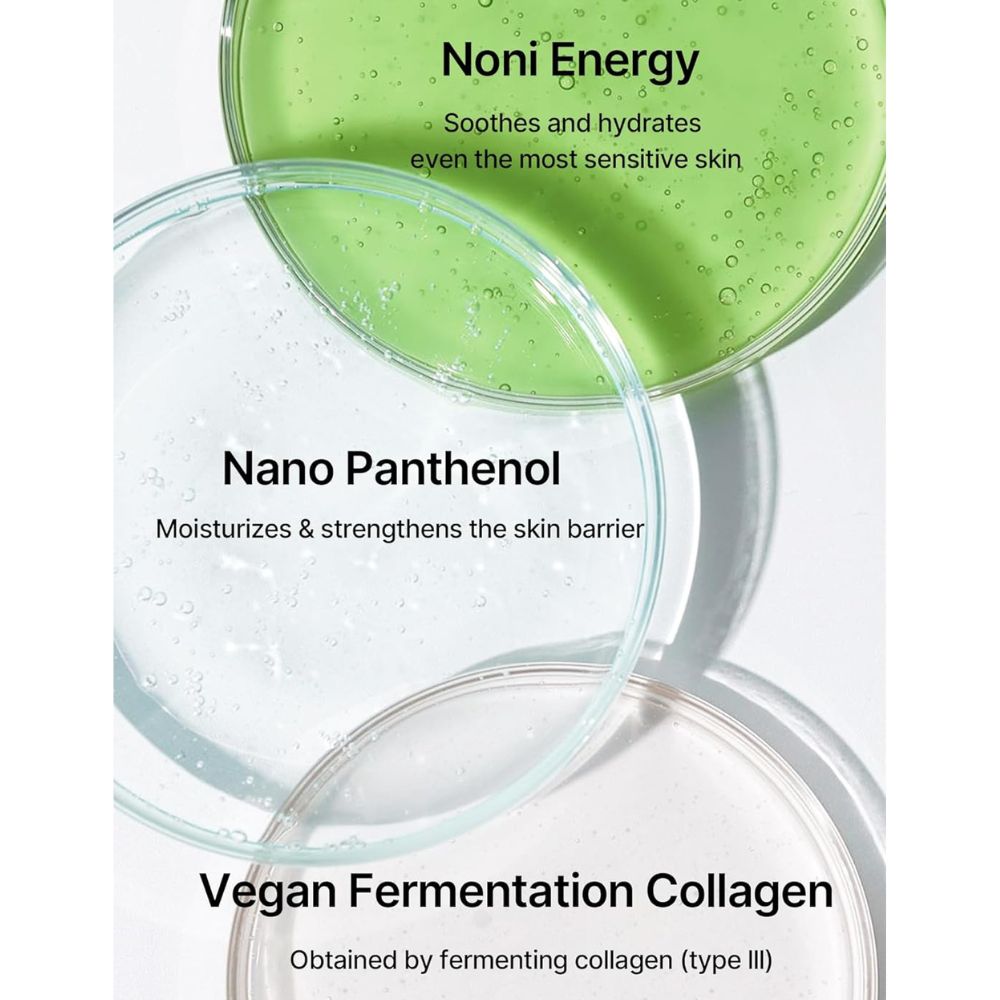

Celimax Noni Energy Repair Ampoule VARIANTA MINI este un ser concentrat care redă pielii vitalitatea, hidratarea și luminozitatea de care are nevoie zilnic. Textura sa lejeră și formula bazată pe ingrediente naturale îl fac un aliat de încredere pentru menținerea unui ten sănătos și revitalizat, chiar și în cazul pielii sensibile.
Beneficii produs
-
Hidratează intens și oferă un aspect radiant încă de la primele utilizări.
-
Îmbunătățește elasticitatea și contribuie la un ten mai ferm.
-
Calmează iritațiile și redă confort pielii obosite.
-
Susține regenerarea celulară și uniformizează aspectul pielii.
-
Este potrivit pentru toate tipurile de ten, inclusiv cel sensibil.
Ingrediente active Celimax Noni Energy Repair Ampoule VARIANTA MINI
-
Extract de Noni (71.77%) – bogat în vitamine și antioxidanți, ajută la hidratarea profundă și intensifică luminozitatea naturală a pielii.
-
Ulei de Rozmarin – recunoscut pentru efectele sale calmante și revitalizante, oferă prospețime și confort pielii.
-
Colagen Vegan – sprijină menținerea elasticității cutanate și întărește bariera naturală de protecție.
-
Adenozină – ingredient activ cu rol anti-rid, reduce vizibil liniile fine și contribuie la un aspect întinerit al pielii.
-
Formulă curată – fără coloranți artificiali, blândă și sigură chiar și pentru pielea sensibilă.
Acest ser hidratant cu extract de noni se absoarbe rapid, fără senzație lipicioasă, lăsând pielea catifelată și plină de vitalitate.
Mod de utilizare
-
Curăță și tonifiază pielea.
-
Aplică câteva picături de ser direct pe față.
-
Masează ușor și tapotează pentru absorbție completă.
-
Continuă cu o cremă hidratantă pentru a sigila efectele.

Valentina (Client SkinGuru) –
Calmant, rămâne însă puțin sticky pe ten mixt/gras